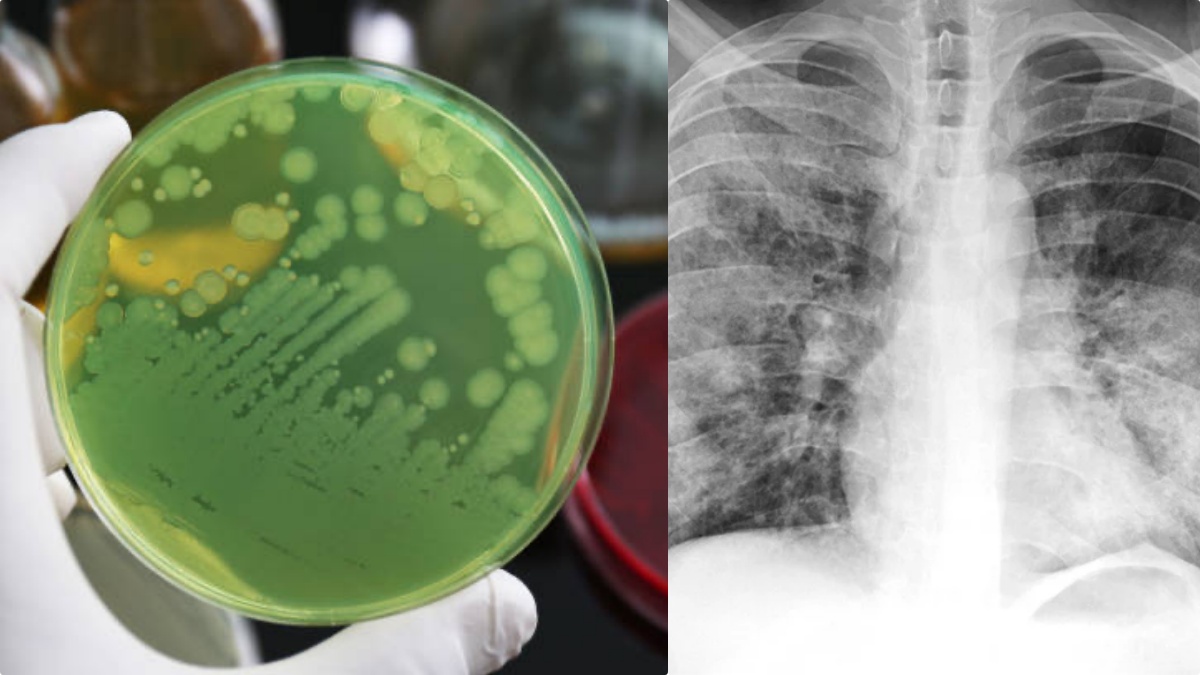

Polmoni sciolti dai batteri Orrore a 33 anni è iniziata con una semplice influenza
La medicina moderna ha appena riscritto i confini dell’impossibile tra le mura del Northwestern Memorial Hospital di Chicago. Quello che era iniziato come un banale episodio influenzale si è trasformato in una sfida clinica senza precedenti, portando un’equipe di chirurghi a compiere un passo estremo: mantenere un uomo in vita con il torace completamente vuoto. Per ben 48 ore, un paziente di 33 anni ha continuato a esistere senza polmoni, affidando le proprie funzioni vitali a una tecnologia d’avanguardia mentre il suo organismo cercava di vincere una battaglia disperata contro una sepsi devastante. Il caso, recentemente documentato sulla rivista Med e ripreso da Nature, rappresenta una pietra miliare nel campo dell’ingegneria biomedica.🔗 Leggi su Thesocialpost.it
Notizie correlate
Influenza o semplice raffreddore? Ecco come capirlo dai sintomi
Con l'aumento dei casi di influenza in Italia, distinguere tra influenza e raffreddore diventa fondamentale.
Cade nel fiume senza protezioni e viene divorata dai piranha: orrore in Amazzonia, morta una bimba di due anni
Contenuti e approfondimenti
Si parla di: Terremoto in Italia, una scossa dietro l’altra. Tanto spavento.
A 33 anni sopravvive per due giorni senza polmoni, sciolti dai batteri: l'influenza, poi la sepsi e l'intervento straordinarioTutto è iniziato con una banale influenza, ma si è trasformato in un incubo clinico che ha costretto i medici del ... msn.com
Giovane tenuto in vita per due giorni senza polmoni, liquefatti da una sepsi: ora sta bene. Come hanno fattoI medici del Northwestern Memorial Hospital hanno salvato un giovane grazie a un intervento straordinario, che ha permesso di mantenerlo in vita senza ... fanpage.it
Ulteriori sei mesi di commissariamento per il Municipio i cui organi elettivi sono stati sciolti per infiltrazioni mafiose. Ecco tutte le opere pubbliche avviate dai commissari e la riorganizzazione dei servizi. Importanti novità per la polizia locale, l’edilizia residenzial - facebook.com facebook